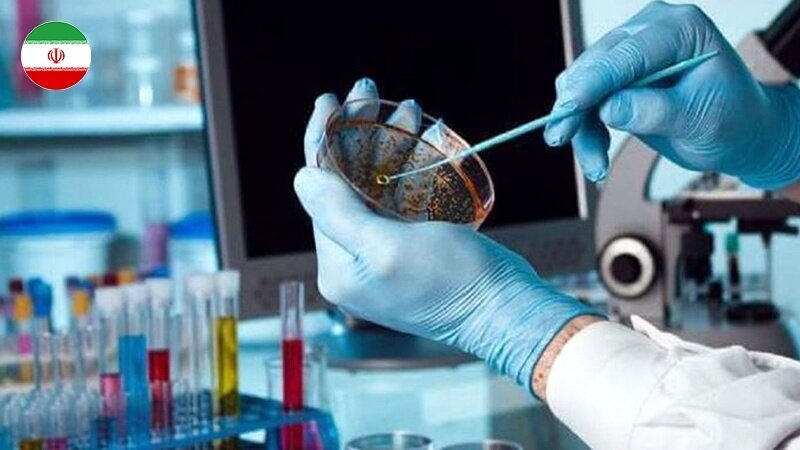
Fortschritte bei der Diagnose von Darmkrebs mit iranischem Kit

Die Nachrichtenagentur IRIB zitierte am Donnerstag Omran Emami, den Technologie-Hersteller dieses wissensbasierten Produktes in Isfahan, im Zentrum Irans: „Das auf neuen Technologien basierende Kit zur Diagnose von Magen-Darm-Krebs ist ein wissensbasiertes Produkt, das nach 8 Jahren Forschung kurz vor der Kommerzialisierung steht und zu einem Drittel des Preises der amerikanischen und chinesischen ausländischen Proben hergestellt werden kann“.
Omran Emami fügte hinzu: „Die derzeit auf dem Markt erhältlichen Diagnosekits für Magen- und Darmkrebs können nicht genau bestimmen, ob es sich um einen krebsartigen oder nicht krebsartigen Tumor handelt, während das wissensbasierte Magen- und Darmkrebs-Diagnosekit dieses Unternehmens eine Diagnosegenauigkeit von über 90% für krebsartige und nicht krebsartige Tumore aufweist.
342/

Your Comment